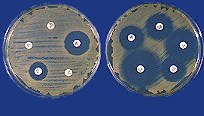
antibiod.jpg

|
|
Els antibiòtics són substàncies químiques elaborades per alguns microorganismes, que danyen o maten a uns altres microorganisme. Els antibiòtics no maten els virus. La majoria de substàncies antibiòtiques són productes naturals que certes bactèries i fongs produeixen i envien fora de la cèl·lula. Aproximadament
el 90% dels antibiòtics s'obtenen de les bactèries. Existeixen alguns antibiòtics, però que són completament sintètics, estan fabricats en els laboratoris. Aquests
particulars antibiòtics estan dissenyats per impedir alguns processos prèviament identificats en alguns bacteris, i que són necessaris per mantenir-los vius. |
 |
Imatge
obtinguda amb el microscopi electrònic, on es pot observar l'acció d'un antibiòtic bactericida sobre un staphylococus aureas, a la part superior esquerra. |
|
|
 |
|
|
|
La relació entre els éssers humans i la malaltia que produeixen els gèrmens és d'antibiosi. Si una persona és afectada per gèrmens, aquest és l'organisme afectat; si l'atac és rebutjat per les defenses del cos, els gèrmens són el organismes afectats. Quant el sistema de defensa d'una persona no pot controlar l'antibiosi ,al seu favor s'ha de recórrer als antibiòtics per desequilibrar la balança en direcció a la salut. Els
antibiòtics és classifiquen bàsicament en dos grans grups : els bateriostàtics i els bactericides. Els antibiòtics bacteriostàtics s'introdueixen en els microorganismes i impedeixen la reproducció bloquejant diverses estructures, com els ribosomes encarregats de fabricar les proteïnes de l' organisme bacterià o els àcids nucleics que en regeixen el procés de reproducció. Els
antibiòtics bactericides actuen alterant la permeabilitat de la paret cel·lular del germen o bloquejant la fabricació de proteïnes essencials per a la seva estructura , de manera que la paret acaba col·lapsant-se o esclatant. |
|
|
|
 |
|
|
|
Es denomina espectre d'acció la gamma d' espècies de microorganismes contra el que actua un determinat antibiòtic. Alguns
antibiòtics es consideren de petit espectre o espectre reduït, perquè actuen específicament contra un nombre determinat de microorganismes. Al contrari, altres antibiòtics, es consideren d'espectre ampli perquè actuen contra una gran varietat de microorganismes. Com
que l'acció d'un determinat fàrmac antibiòtic només serà efectiva contra un grup concret de gèrmens i ineficaç contra la resta, sempre s'han de precisar les indicacions. En aquest sentit, cal destacar el perjudici comporta l'automedicació de fàrmacs d'aquesta mena, l'administració del quals sempre ha d'ésser indicada pel metge, un cop realitzada la diagnosi etiològica de la infecció |
|
|
|
 |
|
|
|
És un mètode per estudiar la sensibilitat del gèrmens als antibiòtics. No és necessari en tots els casos d'infecció, sobre tot quan aquesta sensibilitat és coneguda. Però sí es indispensable quan l'infecció és molt greu.  Per realitzar-ho es recull una gota de líquid d'un cultiu de bacteris en suspensió, i es posa la gota en un plat Petri que conté agar i nutrients. Amb una vareta estèril de vidre, inclinada 90 graus, s'expandeix tota la gota per la superfície de l'agar. Aleshores, uns petits discs circulars, saturats tots amb diferents antibiòtics, es col·loquen al plat amb una distància equidistant uns dels altres. El plat és incubat a una temperatura adequada, i es mira les zones del voltant, en què no ha hagut creixement. Si el bacteri és resistent a l'antibiòtic, hi haurà un creixement al voltant del disc. El germen és més sensible a l'antibiòtic quant més gran és el diàmetre de la zona d'inhibició. Un germen és Per realitzar-ho es recull una gota de líquid d'un cultiu de bacteris en suspensió, i es posa la gota en un plat Petri que conté agar i nutrients. Amb una vareta estèril de vidre, inclinada 90 graus, s'expandeix tota la gota per la superfície de l'agar. Aleshores, uns petits discs circulars, saturats tots amb diferents antibiòtics, es col·loquen al plat amb una distància equidistant uns dels altres. El plat és incubat a una temperatura adequada, i es mira les zones del voltant, en què no ha hagut creixement. Si el bacteri és resistent a l'antibiòtic, hi haurà un creixement al voltant del disc. El germen és més sensible a l'antibiòtic quant més gran és el diàmetre de la zona d'inhibició. Un germen és sensible quan és inhibit per un tractament de dosis habituals. Un germen no serà atacat per tals dosis. Els gèrmens es classifiquen en: sensibles, resistents i intermitjos. Aquest procés permet escollir un antibiòtic o un altre. sensible quan és inhibit per un tractament de dosis habituals. Un germen no serà atacat per tals dosis. Els gèrmens es classifiquen en: sensibles, resistents i intermitjos. Aquest procés permet escollir un antibiòtic o un altre. |
|
|
|
|
|
|
|
 |
|
ANTIBIÒTIC |
DESCOBRIDOR |
ORIGEN |
ORGANISMES O MALALTIES QUE COMBAT |
Penicil.lina |
Fleming (1929); Florey Chain (1940)
|
Penicillium notatum, P. chrysogenum
|
Actinmices bovis, Bacillus anthracis, B. subtilis, Clostridium, Corynebacterium diphtheriae, Hemophilusw influenzae, Micrococcus pyogenes (estafilococ) , Neisseria, Streptococcus, Treponema pallidum.
|
Actinomicetina |
Grafia, Dath (1924); Welch (1937) |
Streptomyces albus |
Bacillus megatrium, B. subtilis,candida pulcherrina, corynebacterium diphtheeriae, micrococcus lysodeikticus, M. pyogenes (estafiloococ), Sarcia lutea, streptococcus pneumoniae (pneumococ), S. pyogenes |
Actinomicines |
Wakman, Woodruf (1940) |
Streptomyces antibioticus |
Malaltia de Hodgkin i lleucèmies; tumors malignes de la infància. |
Bacitracina |
Johnson, Anker, Meleney (1945) |
Bacilius licheniformis |
Clostridiumm novyi, Cl. perfringens, Cl. seepticum, Corynebacterium diphtheriae, Micrococcus pyogenes (estafiilococ), Neisseria gonoorrhoeae (gonococ), N. meningitidis (meningococ), Streptococcus, Treponema pallidum. |
Cefalosporina |
Brotzu (1945) |
Ceephalossportium sp |
Actinomices, Corrynebacterium diphtheriae, Micrococcus, Neisseira, Streptoococcus. |
Cicloserina. |
Harned,Kroop (1955) |
Streptomyces orchiaacaceus. S. garyphalus |
Mycobacterium tuberculosis. |
Cloranfenicol |
Ehrlich (1947) |
Streptomyces venezuelae [i sintesi] |
Brucella, Escherichia, Homophilus, Klebsiella, Proteus, Slomonella, Shigella, rickèttsies, virus psitacosi-limfogranuloma |
Colimicina |
Brownlee, Jones (1948); Koyama (1952) |
Bacillus polymyxa |
aprox. polimixina |
Eritromicina |
Mc Guuire(1952) |
Streptomycess erytthreus |
aprox. penicil·lina |
Estreptomicina |
Waksman (1944) |
Streeptoomyces griseus |
Eccherichia, Hemophilus, Klebsiella, Micrococcus pyogenes( genococ) Mycobacterium tuberculosis, Pasteurella pestis, P.tularensis, Pseudomonas aerugginosa. |
Griseofulvina |
Oxford (1939) |
Penicillium griseofulvum. P. jamczewskii |
Infeccions fungiques. |
Kanamicina |
Umezawa (1957) |
Streptomyces Kanamicetycus |
Escherichia, Hemophilus, Klebsiella, Micrococcus pyoggenes (estafilococ), Mycobacterium tuberculosis, Salmonella tuphi, Sighella, Streptococcus. |
Neomicina |
Waksman, Lechevalier.(1949) |
Sttreptomyces fradiae. |
Escherichia, Hemophilius influenzae, Klebsiella, Micrococcus puogenes (estafilococ) Mycobacterium tuberculosis,, Salmonella typh, Sighella, Streptococcus. |
Nistatina |
Hasen, Brown (1951); Dutcher (1954) |
Streptomyces noursei |
infeccions fúrgiques. |
Novobiocina |
Smith, Wallick (1956) |
Streptomyces niveus, S. spheroides |
Corynebacterium diphteriae, Hemophilus influenzae, Micrcoccus pyogenes (etafilococ), Neisseria gonorrhoeae (gonococ) N. Meningitis(meningococ),Streptococcus pneuminae ( pneumococ) |
Oleandomicina |
Sobin(1954) |
Streptomycides antibioticus. |
Bacillus annthracis, B. Subtilis, Clostridium, |
|
|
 |
|

Imatges amb llum polaritzada de cristalls de: AMOXICIL·LINA |
Entre els antibiòtics bactericides més importants hi ha el grup de les penicil.lines i derivats, que entre altres hi inclou la penicil.lina G, l' ampicil.lina i l' amoxicil.lina,les cefalos-porines i el grup dels aminoglucòsids, que entre d'altres comprèn l' estreptomicina,la tobramicina, l' amikacina, la neomicina i la gentamicina. |

Imatges amb llum polaritzada de cristalls de: AMPICIL·LINA |
|
|
L'acció
de la penicil·lina es mostra en aquesta figura, que representa una zona "central" neta al mig de la qual es troba una colònia del fong Penicillium notatum crescuda en medi agar 5 ó 6 dies que prèviament havia estat cobert amb una fina pel·lícula d'un altre agar que contenia cèl·lules del bacteri groc Micrococus luteus. La producció de penicil·lina per part del fong ha creat una zona d'inhibició del creixement d'aquest bacteri. Aquesta demostració és semblant a la que va observar originalment Alexander Fleming, tot i que ell va veure la inhibició del creixement i el trencament cel·lular del bacteri Staphylococus aureus en la zona de cultiu que havia estat contaminada amb per una colònia de P.notatum. Aquesta
és una figura que mostra l'estructura asexual típica, portadora de les espores, d'algunes espècies de Penicillium. Les espores s'originen en cadenes a partir d'unes cèl·lules especials anomenades fiàlides que es troben prop de l'àpex de l'estructura aèria del fong. D'altra
banda , alguns antibiòtics , classificats com a antibiòtics fungistàtics , actuen impedint la reproducció de diverses espècies de fongs, com Candida albicans , Histoplasma capsulatum o Blastomyces dermatitidis. S' hi inclou, per exemple , l' amfoteriina B, el cetonazol, el fluconazol, l' itraconazol, el miconazol, la fluorocitosina, la griseofulvina i la nistatina. La
ineficàcia dels antibiòtics en cas de malaties infeccioses d' origen víric és deguda al fet que els virus no disposen ni de paret cel.lular, per la qual cosa no poden ésser eliminats pels antibiòtics bactericides, i el fet que les estructures víriques que participen en el procés de reproducció són massa senzilles perquè els antibiòics bacteriostàtics que hi ha actualment els puguin afectar. L'
administració dels antibiòtics adequats col·labora substancialment en l' eliminació o l' aturada de processos infecciosos específics contra els quals són indicats. No obstant això, perquè els gèrmens efectivament siguin eliminats completament, cal la participació del sistema defensiu de l'organisme. Per aquesta raó, l' antibioticoteràpia en malalts immunodeprimits, com per exemple els individus que pateixen de SIDA, leucèmies, limfomes o la malaltia de Hodgking, no sol ser eficaç. |
|
|
|
|
|
Colonia d'actinomycets, Streptomyces griseus, vista amb microscopi amb un augment de 10 vegades
Alta amplificació de les hifes aèries i espores seques
|
 |
L'enorme èxit de la penicil·lina va portar a la recerca d'altres microorganismes productors d'antibiòtics, especialment entre els fongs del sòl. Un d'aquest descobriments(1943) va ser el de l'estreptomicina a partir d'un actinomicet del sòl, Streptomyces griseus. Com es veu a la figura de baix, els actinomicets són fongs que produeixen un gran nombre d'espores seques i polsoses a partir de les hifes aèries. A
més de la penicil·lina, hi han altres antibiòtics molt importants com les cefalosporines (amb beta.lactats molt semblants a la penicil·lina però menys al·lergènics) i la griseofulvina (Penicillium griseofulvum) que és usat en el tractament del peu d'atleta i altres infeccions micològiques de la pell. |
|
|
 |
|
|
|
De l'exposat es dedueix que els antibiòtics aplicats als aliments en molt petites dosis, inferiors a les profilàctiques, poden prolongar per varis dies el bon estat dels aliments frescs, però amb l'auxili de la baixa temperatura, sense arribar a un refrigerat intens. No serveixen però per a una preservació permanent. Però
ara bé, és possible d'utilitzar els antibiòtics sense perill per als consumidors?.Ens trobem davant un problema semblant al dels preservadors químics, encara que, en aquest cas, es tracta de substàncies menys perilloses i s'utilitzen en menor proporció. Però, recordem que la seva acció és principalment bacteriostàtica i no universal, és a dir, que existeix el perill de què es trobin presents bactèries resistents a la seva acció que es desenvolupa en els aliments o quan es barregen amb altres en la cuina familiar, per al consum. També existeix la possibilitat de què els sensibles, passat l'efecte dels antibiòtics( que la seva acció és relativament breu) tornin a la seva acció i facin perillós l'aliment contaminat. A més s'ha de tenir en compte el perill de la sensibilitat personal als antibiòtics, bastant comú per a alguns d'ells, i menor per a les tetracilines i cloromicetina. Tenint
en compte això, les autoritats sanitàries només han acceptat la seva addició en alguns casos en els que s'ha demostrat que no queden en l'aliment quan aquest es ingerit. Els primers països que van acceptar el seu ús per a aus crues, van ser Canadà i els Estats Units. |
|
|
|
|